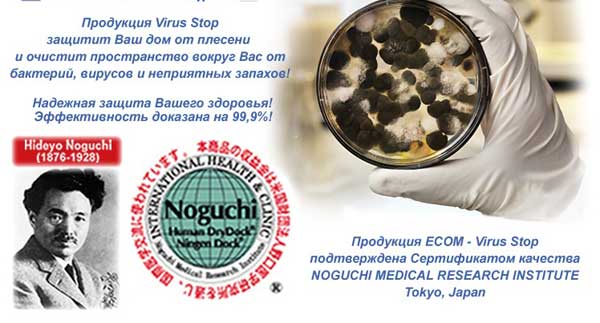

Спрей против вирусов и бактерий для помещений
Воздухоочиститель от вирусов и бактерий представляет собой высокотехнологичный прибор, разработанный для использования в частных домах и квартирах многоэтажек. Сейчас устройства с такими функциями более чем актуальны в связи с началом эпидемии коронавируса COVID-19. Возникает вопрос: способен ли такой очиститель помочь в профилактике заболевания? Как он работает, насколько эффективен по сравнению с другими средствами?

Способы распространения вируса: кратко о главном
Чтобы ответить на указанные выше вопросы, сначала необходимо вспомнить, какими способами распространяются вирусы, сходные с COVID-19:
- воздушно-капельный (когда капельки слизи и слюны при чихании и кашле разлетаются, как шрапнель на расстояние до 2 метров);
- контакт с зараженными поверхностями и инфицированными (когда после попадания инфекции на кожу, человек прикасается к лицу и происходит заражение через слизистые носа, рта и глаз);
- воздушно-пылевой (когда вирус попадает на частицы пыли, которые разносятся на большое расстояние и попадают в организм при дыхании).
Коронавирус COVID-19 способен передаваться всеми перечисленными способами. Это способствует высокой скорости его распространения.


Коронавирус: никогда такого не было, и вот – опять!
12 марта 2020 года Всемирная Организация Здравоохранения, изучив данные о темпах распространения коронавируса COVID-19, признала коронавирус пандемией – эпидемией в мировом масштабе. На 15 марта 2020 года в мире насчитывается почти 160 000 зараженных, около 6000 человек погибло. Выздоровело более 75 000 человек.

В России на 20 марта зафиксировано 200 случаев заражения коронавирусом. Нужно отметить – речь идет об официально подтвержденных больных. Так как инкубационный период у COVID-19 составляет от 5 дней до 1 месяца, реальные масштабы эпидемии пока неизвестны.

Признаки похожи на симптомы при пневмонии. Обычно всё начинается с тяжелого, изматывающего кашля. По мере развития болезни возникают затруднения при дыхании. Возможна потеря сознания. Остальные признаки заболевания коронавирусом похожи на симптоматику при вирусных (ОРВИ) и бактериальных (ОРЗ) заболеваниях:
- озноб, высокая температура (38 °С и выше);
- боль в груди;
- слабость, общее недомогание;
- головная и мышечная боль.
Если вы подозреваете, что заболели коронавирусом, не теряя времени, обратитесь к врачу для проведения теста. Для этого достаточно сдать кровь и мазок со слизистой носа.

К сожалению, лекарства от COVID-19 на сегодняшний момент не существует, так же, как и вакцины. Китай заявил, что препарат в процессе разработки, однако конкретные даты его запуска в производство не обозначены. Врачи рекомендуют использовать противовирусные препараты общего действия.

- отказаться от посещения людных мест;
- ограничить общение;
- по возможности отменить поездки в места с неблагоприятной эпидемиологической ситуацией;
- при выходе из дома надевать медицинскую маску;
- чаще мыть руки, регулярно делать дома влажную уборку и дезинфицировать часто используемые предметы – смартфон, бумажник, ключи.
Допустим, вы предпринимаете все возможные меры предосторожности, чтобы защититься от заражения. Придя домой, вы хотите быть уверены, что в его стенах вы в безопасности.
Однако дома вас может ждать другая опасность – носителем инфекции могут стать один из ваших домочадцев. Даже если это произошло, не стоит поддаваться панике.
В первую очередь необходимо максимально снизить риск заражения всех остальных, ведь с вами могут проживать ваши родители или родственники с ослабленным здоровьем – для них эта инфекция значительнее опаснее.
Разумеется, в такой ситуации производится госпитализация заболевшего, его изоляция. Но не стоит забывать о длительном (до 2 недель) инкубационном периоде коронавируса – человек может распространять инфекцию и даже не подозревать об этом.
Заражение в большинстве случаев происходит воздушно-капельным путем, поэтому опаснее всего находиться вместе со скрытым больным в закрытых, непроветриваемых помещениях.
К примеру, если один из членов семьи является носителем вируса, при совместном проживании в описанных условиях вероятность передачи инфекции составляет 99%.

Речь идет о следующих устройствах:
- мойки воздуха с водяным барабаном;
- ультрафиолетовые лампы;
- воздухоочистители, оснащенные вентилятором и встроенным фильтром;
- бактерицидные лампы с увиолевым стеклом;
- амальгамные лампы;
- рециркуляторы с функцией очистки воздуха.
Допустим, что вы приобрели очиститель воздуха от вирусов для квартиры, который действительно способен бороться с ними – если они будут в атмосфере дома, то он их добросовестно нейтрализует.

Это действительно так. Во время отопительного сезона в большинстве квартир воздух такой же сухой, как в пустыне Сахара (15-17% влажности). Отметим – рекомендуемый уровень влажности – 40-50%.
Проблема сухого воздуха в том, что он пересушивает слизистые дыхательных путей, делая их беззащитными перед атаками вирусов и вредоносных бактерий.
Есть и другая причина. При кашле и чихании в атмосферу помещения выделяется поток микрочастиц слюны и слизи. Это похоже на струю аэрозоля. При нормальной влажности (50-60%) эти частицы сохраняют свой вес и достаточно быстро оседают на пол. В атмосфере с недостатком влаги они сразу разбиваются на еще меньшие частицы, которые могут плавать в воздухе часами и даже днями.

В день мы пропускаем через свои лёгкие от 8 до 15 кубометров воздушной смеси (если перевести на вес, то это будет 10-18 килограмм!). Представьте, сколько грязи и микроорганизмов попадет в организм с таким объёмом воздуха.
Итак, воздух в квартире можно и нужно увлажнять. Но тут есть один нюанс – если зимой поднять в доме уровень влажности, а потом открыть окно, то процент влаги в атмосфере помещения резко упадет. Можно целый день доводить влажность до рекомендуемых 50%, а потом вся накопленная влага за пару минут вылетит в форточку.
Подведем итог. Получается, что очистители воздуха и увлажнители бесполезны, если в доме нет нормального воздухообмена.
Одной из таких решений является установка вентиляции, который ко всему прочему имеет функцию очистителя воздуха от бактерий и вирусов.

Проветриватель OXY: выбор расчетливых
Для тех, кто собирается купить очиститель воздуха от вирусов и бактерий, стоит присмотреться к OXY. Эта российская марка. Устройства серии OXY разработаны в соответствии с особенностями нашего климата и обладают следующими ключевыми преимуществами:
- сочетают в себе эффективную приточную вентиляцию и круглосуточную защиту от вирусов;
- оптимальны в плане соотношения цены и функционала;
- просты в монтаже, устанавливаются за час, даже по чистовому ремонту;
- надежны – изготавливаются из немецких комплектующих, отличаются высоким качеством сборки.
OXY обеспечивает в доме эффективный воздухообмен, что позволяет в разы снизить риск заболеваемости друг от друга.

А еще вентиляция OXY – идеальный вариант для тех, кто не готов платить за ненужные ему функции. Серия представлена тремя моделями, и каждая из них отличается от остальных по своим возможностям и стоимости.

- OXY. Работает без электричества (воздух поступает в квартиру самотёком). Оснащен пылевым фильтром, имеет компактные размеры и стоит всего 3990 рублей;
- OXY 2. В конструкцию очистителя входит электровентилятор, есть несколько режимов подачи воздуха – можно установить нужную производительность (до 150 м3/час). В комплектацию входит пылевой фильтр класса G4;
- OXY 3. Оснащен надежным и экономичным (27 Вт) немецким вентилятором с регулировкой скорости работы, нагревателем воздуха с мощностью до 1 кВт. Пылевой фильтр класса F5, угольный G4.

Еще одна важная деталь – воздухоочистители этой марки являются модульными устройствами. Это означает, что, установив OXY, вы всегда можете провести его апгрейд до более функциональных моделей OXY 2 или OXY 3. Замена производится за 1 час.

Серия ECOM предназначена:
- очищения пространства вокруг вас от вирусов и токсинов и бактерий
- очищения и обеззараживания поверхностей, включая слизистые ( горло и нос) руки. фрукты и овощи.
Рекомендации по применению
- установить в помещении, холодильнике, машине и т.д.
- взять в дорогу, протирать руки перед едой обеззаразить общественные места ( компьютер, телефон, ручки багажа), фрукты и овощи, поверхность стола и т.д.
Cерия REBION предназначена:
- для укрепления естественной защиты организма
- для эффективной борьбы с инфекциями (вирусными, бактериальными, грибковыми)
Рекомендации по применению
- Распылять в помещении 2-4 раза в день. Для максимальной эффективности рекомендуется использовать средства перед проведением влажной уборки помещения. Подробнее.

имеют компактный размер и небольшой вес, что позволяет без труда разместить их в удобных местах. Они используются для дезинфекции воздуха:
- в помещении (комната, офис, класс, зал и т.п.)
- в закрытом пространстве (ящик, шкаф, холодильник и т.п.)
- в транспорте (кабина, салон автомобиля)
Эти средства представляют собой пластиковый корпус, в который помещается пакет с действующим 2-3 месяца веществом .
Портативные средства защиты от вирусов и бактерий представлены пятью моделями.
Каждая модель предназначена для использования в определенных местах и имеет отличающиеся технические характеристики.
Они не требуют электропитания и являются продуктами одноразового использования.
ECOM Stand
применяется в помещениях: детская , офис, ванная и санузел. Уменьшает воздействие возбудителей аллергии (таких как пыльца растений), облегчит жизнь людей страдающих астмой, удаляет неприятные запахи, обладает дезинфицирующим эффектом, убивает грибок.

ECOM Cool
предназначена для дезинфекции пространства внутри холодильной камеры холодильника. В морозильных камерах не используется!

ECOM Box
применяется для дезинфекции небольших закрытых объемов, например, шкафов. В комплекте с этой моделю поставляется липучка, которая позволяет закрепить продукт на внутренней поверхности шкафа.

ECOM Car
применяется для дезинфекции пространства в салоне автомобиля.

Срок годности упаковки с действующим веществом во всех моделях составляет 1 год. Эффективный радиус и срок действия вещества зависят от модели. Эти параметры можно посмотреть в описаниях к ним



Мы все уже усвоили, как важно в условиях разгула любой инфекции держать в чистоте свои руки. Но многие забывают, что дезинфицировать нужно и поверхности, к которым вы прикасаетесь. Каждый раз, возвращаясь с улицы, вы трогаете дверные ручки, выключатели, ручки шкафов – множество предметов, на которых могут остаться патогены. Чтобы не протирать их каждый час, лучше использовать средства для дезинфекции от коронавируса с пролонгированным действием, способные обеспечить защиту в течение нескольких часов.
Роспотребнадзор рекомендует использовать в качестве дезинфицирующих средств от коронавируса антисептики на основе спирта (не менее 60-70%) или хлора. Средства на основе хлора советуют применять при обработке ванной комнаты, а также при влажной уборке в доме, где живет больной человек. В остальных случаях предпочтительнее спиртовые антисептики, как более безвредные. В наш рейтинг лучших средств для дезинфекции от коронавируса в 2020 году вошли и те, и другие.
Рейтинг топ-10 по версии КП

Этот антисептик на основе спирта подходит как для обработки рук, так и для дезинфекции поверхностей в квартире в условиях коронавируса. Он быстро высыхает и не требует смывания водой. Однако, если вы обрабатываете им поверхности, которые контактируют с пищей: разделочные доски, посуду, кухонные столы - тогда производитель советует смыть антисептик. Pro-Brite CLF легко воспламеняется, так что не стоит пользоваться им возле открытого огня.
В применении он очень прост: нужно распылить средство на поверхность или смочить им салфетку, если поверхность не очень большая. Некоторые пользователи отмечают, что у Pro-Brite CLF присутствует характерный запах спирта, но он быстро выветривается.
Основные характеристики: объем от 1 до 5 литров, главное активное вещество – изопропиловый спирт ≥65% - соответственно, средство эффективно в отношении COVID-19.

Основные характеристики: объем 250 мл, 500 мл и 5 литров, главное активное вещество – изопропиловый спирт 66%, в составе также присутствует глицерин – компонент, который ВОЗ считает необходимым в антисептиках против коронавируса.

Основные характеристики: объем 1, 5 и 10 литров, главное активное вещество – изопропиловый спирт 70%, в составе также присутствует глицерин.

Салфетки – это удобное средство для дезинфекции, если у вас небольшая квартира или рабочий кабинет. Если же вам нужно обрабатывать большую площадь, то салфетки - не слишком выгодный вариант и лучше выбрать жидкий антисептик в бутылке.
Основные характеристики: упаковка на 50 штук, каждая салфетка содержит изопропиловый спирт – 70%, дидецилдиметиламмоний хлорид – 0,23% (ЧАС с хорошими моющими свойствами), а также смягчающие компоненты для кожи рук.

Производитель уточняет, что салфетки изготовлены из нетканого материала, поэтому не оставляют после себя волокнистых компонентов и не вызывают аллергических или местно-раздражающих реакций, если обрабатывать с их помощью руки.
Основные характеристики: салфетки продаются и по одной штуке, и упаковками, например, на 20 или 400 штук, они пропитаны 70-процентным раствором этилового спирта.

Кроме того, создатели дезсредства уверяют, что после использования оно полностью разлагается до пресной воды, не создает пленок на поверхностях и не требует смывания (если им не обрабатывали кухонные принадлежности).
Основные характеристики: готовый раствор, выпускается в канистрах объемом от 500 мл до 5 литров, в основе действия - смесь высокоактивных хлоркислородных и гидропероксидных соединений.

Основные характеристики: концентрат, выпускается в бутыли объемом 1 литр, в его составе: алкилдиметилбензиламмоний хлорид (АДБАХ) 5% (четвертичное аммониевое соединение с хорошими моющими свойствами), глиоксаль 8% (дезинфектант широкого спектра) и ПАВы.

Еще одно средство для дезинфекции от коронавируса на основе хлора. Хлорамин Б — это товарное название бензолсульфохлорамида натрия. Выпускается он в виде белого или слегка желтоватого порошка со слабым запахом хлора. Хлорамин Б действует и как антисептик, и как дезодорирующее средство. Однако важно знать, что Хлорамин Б относится к 3 классу опасности – его используют только со средствами защиты кожи и когда рядом нет людей, так что увлекаться им не стоит.
Основные характеристики: порошок для приготовления раствора, выпускается в пакетах от 300 граммов до 15 кг, содержание активного хлора - 26%, класс токсичности – 3.

Продолжая список дезинфицирующих средств с хлором, сложно упустить это средство для обработки ванной комнаты. Sanfor Universal выпускается в форме геля, который более экономичен в применении, нежели жидкие дезинфицирующие вещества. В нем присутствуют несколько вариантов отдушек, которые помогают замаскировать запах хлора. К тому же Sanfor Universal помогает справиться не только с вирусами и бактериями, но и уничтожает плесень, известковый налет и неприятные запахи. Многие пользователи отмечают, что лучше всего чистить им ванну в резиновых перчатках, так как средство может разъедать кожу.
Основные характеристики: в линейке есть не только гели, но и дезинфицирующие спреи Sanfor, объем – 750 мл, в составе - гипохлорит натрия (калия) от 5 до 15%.

В нашем списке это средство выделяется своей формой. Пенное мыло Sarasoft RF помогает дезинфицировать руки, а также любые поверхности в доме, включая посуду. Производитель уверяет, что мыло уничтожает стафилококки, вирусы гриппа, гепатита, вирусы герпеса и прочие патогенные микроорганизмы. Sarasoft RF обладает нейтральным pH и не имеет запаха, что делает его хорошим вариантом для обработки кухонных принадлежностей.
Основные характеристики: выпускается во флаконах на 250 мл, 1 литра и 1,2 литра с дозатором, действующее вещество: полигексаметиленбигуанидин гидрохлорид 0,55% - вещество с выраженным биоцидным, фунгицидным и вирулицидным эффектом.
Как выбрать средства для дезинфекции от коронавируса?
В нынешних условиях многие из нас столкнулись с необходимостью приобрести подобные антисептические средства, вот только сейчас это уже не так просто. Большинство препаратов раскупают так стремительно, что некоторым остается приобретать, что осталось. Тем не менее, если выбор у вас все же есть, мы подскажем, на какие моменты лучше всего обратить внимание при подборе лучшего средства для дезинфекции от коронавируса в 2020 году.
Внимание на состав
Как мы уже говорили выше, Роспотребнадзор дал довольно четкие указания по поводу того, какие действующие вещества особенно неприятны для коронавируса. Это, во-первых, спирт в концентрации не менее 60 процентов, а во-вторых, хлор. Убедитесь, что в выбранном вами дезсредстве есть либо одно, либо другое. А вот эффективность у хлоргексидина, например, низкая, так что охотиться за ним не стоит, как и за настойкой прополиса. Хорошо, если в составе выбранного антисептика присутствуют помимо упомянутых компонентов глицерин и перекись водорода.
Класс опасности
У дезинфицирующих средства есть классы опасности, всего их четыре: 1-й класс — чрезвычайно опасные; 2-й класс — высоко опасные; 3-й класс — умеренно опасные; 4-й класс — малоопасные.
Эти классы определяют уровень токсичности средства, например, средства 1-го класса опасности используют лишь в экстремальных условиях, средства 2-го класса – в защитных костюмах и противогазах, средства 3-го класса, к которым в нашем списке относятся хлорсодержащие средства, – в перчатках, а вот средства 4-го класса могут свободно применяться в быту.
Объем средства
При покупке того или иного антисептика нужно представлять себе, что вы собираетесь обрабатывать, как часто и в каких объемах. Согласитесь, если вы обрабатываете лишь ручки в своей однокомнатной квартире, нет никакого смысла покупать себе 5 литров концентрата, который затем придется еще и разводить водой. Велик риск, что у такого дезсредства быстрее выйдет срок годности, нежели вы успеете его закончить. В подобной ситуации небольшого спиртового антисептика будет достаточно, к примеру, средства для рук. Наносим его на салфетку и протираем поверхности трижды в день.
Сфера применения
Перед тем, как натирать те или иные поверхности выбранным средством, прочитайте рекомендации на упаковке. Некоторые дезинфекторы могут при взаимодействии с определенными материалами давать нежелательный эффект – обесцвечивать их, к примеру. Обычно сфера применения прописана на этикетке.
Не все средства для дезинфекции обладают моющим эффектом, об этом тоже забывать нельзя. Лучше всего моющий эффект выражен у средств, в составе которых есть ПАВы (поверхностно активные вещества), в том числе ЧАС - четвертичные аммониевые соединения, например, дидецилдиметиламмоний хлорид и алкилдиметилбензиламмоний хлорид, а также кислородсодержащие вещества, например, перекись водорода.
Лучше готовый
Многие дезсредства продаются в виде концентрата, который нужно разводить. Готовый антисептик намного удобнее, если вам не хочется заниматься химией или вы не уверены в своих химических навыках. Но в плане финансов концентрат, конечно, более выгоден, так как из него получится больше антисептика.

Дезинфекция помещений от вирусов (в том числе коронавирусов)
Болезнетворные микроорганизмы и вирусы чаще всего передаются контактным путем и воздушно-капельным. Поэтому простудой и гриппом регулярно болеет так много людей. Одни заражаются от коллег по работе, другие – от детей, подхвативших инфекцию в детском саду, третьи – от соседей по очереди в супермаркете.

Цены на дезинфекцию помещений от вирусов
Обработка офисных помещений от вирусов
| Площадь | Стоимость, руб. |
|---|---|
| до 100 м2 | 35,00 |
| 100-500 м2 | 34,00 |
| 500-1000 м2 | 29,00 |
| 1000-2000 м2 | 24,00 |
| 2000-3000 м2 | 19,00 |
| 3000-5000 м2 | 15,00 |
| 5000-10000 м2 | 13,00 |
| 10000-20000 м2 | 11,00 |
| 20000-30000 м2 | 9,00 |
| 30000-50000 м2 | 7,50 |
| 50000-100000 м2 | 6,00 |
Обработка квартир от вирусов
| Кол-во комнат | Стоимость, руб. |
|---|---|
| 1 комн. квартира | от 5 000,00 |
| 2 комн. Квартира | от 5 300,00 |
| 3 комн. Квартира | от 5 600,00 |
| 4 комн. Квартира | от 5 900,00 |
| 5 комн. Квартира | от 6 200,00 |
| МОП (места общего пользования) | от 4 500,00 |
Обработка коттеджей и загородных домой от вирусов
| Площадь | Стоимость, руб. |
|---|---|
| до 100 м2 | от 5 000,00 |
| 100-200 м2 | от 35,00 |
| 200-300 м2 | от 30,00 |
| 300-400 м2 | от 25,00 |
| 400-500 м2 | от 20,00 |
| 500-1000 м2 | от 18,00 |
| 1000-2000 м2 | от 16,00 |
| 2000-3000 м2 | от 14,00 |
| более 3000 м2 | от 12,00 |
При повторной дизенфекции скидка 10 %
Выезд Москва и МО за МКАД до 10 км-БЕСПЛАТНО
свыше 10 км - 20 руб./ 1 км
Минимальный выезд 3500 рублей
COVID-19: новая проблема — проверенное решение
Тема коронавируса COVID-19 остается одной из самых обсуждаемых в СМИ на протяжении нескольких месяцев. В странах Европы, Азии и США количество заболевших людей исчисляется сотнями тысяч. И в любом государстве жители задаются вопросом: как обезопасить себя от этой болезни?
Рекомендации Роспотребнадзора по профилактике коронавирусной инфекции:

Обязательно мойте руки с мылом после прихода домой из магазина, с работы или из других общественных мест

Надевайте одноразовые медицинские маски, не забывая заменять их через 2-3 часа использования

Используйте одноразовые салфетки для прикосновения к ручкам, перилам и другим поверхностям в местах скопления людей

Применяйте дезинфицирующие составы на основе спирта, если не имеете доступа к мылу и воде

Не прикасайтесь к лицу руками, находясь на улице или в общественных заведениях

Собирайте волосы в прическу, отправляясь в места скопления людей

Не пожимайте руки при приветствии

Проветривайте помещения офисов, магазинов или квартир

Пользуйтесь только своими предметами гигиены
Происхождение инфекции до сих пор неясно. Регулярно выявляются новые симптомы заболевания. А ученые не могут дать приблизительные прогнозы развития ситуации, так как человечество столкнулось с этим вирусом впервые. Предприятия закрываются на вынужденные каникулы, люди стараются оставаться дома, а власти – контролировать самоизоляцию и штрафовать нарушителей.
В Москве эпидемия все больше разрастается, и специалисты уверены, что в ближайшие недели положение будет только ухудшаться. Замедление распространения заболевания затруднено следующими факторами:
- густонаселенность мегаполиса;
- перемещения людей внутри города и области;
- возвращение из-за рубежа и из других регионов страны;
- нарушение режима самоизоляции;
- несоблюдение правил гигиены.
Дезинфекция помещений – действенный способ борьбы с COVID-19, любыми вирусами и болезнетворными бактериями. Это главный инструмент для предупреждения новых случаев заражения. Собственникам магазинов, цехов, офисов, других предприятий и учреждений стоит подумать о проведении внеплановых мероприятий по обеззараживанию пространства.
Владельцы обычных квартир или загородных домов тоже могут пригласить специалистов для профессиональной обработки площадей. Такие меры позволят избежать распространения эпидемии, закрытия организации или жилого здания на карантин и отправления людей в инфекционные больницы.
Как долго короновирус живет на разных поверхностях
Наиболее простой способ заражения COVID-19 – воздушно-капельный. Именно в воздух вирусы попадают из организма заболевшего человека: при чихании, кашле и даже обычном дыхании. А уже оттуда – к новому носителю. Кроме того, коронавирус останется на дверной ручке или другом предмете, если больной случайно перенесет его на своей ладони. Следующий, кто дотронется до поверхности, имеет все шансы заболеть.
COVID-19 передается близко контактирующим людям еще до проявления симптомов у переносчика. Он закрепляется на перилах, столах, поручнях, а затем попадает к здоровому человеку через кожу и дыхательные пути. При контакте с поверхностями опасность заразиться намного больше, чем находясь рядом с инфицированным. Именно поэтому важно проводить обеззараживание всех предметов, особенно в помещениях с высокой пропускной способностью и везде, где работают люди.
Читайте также:


